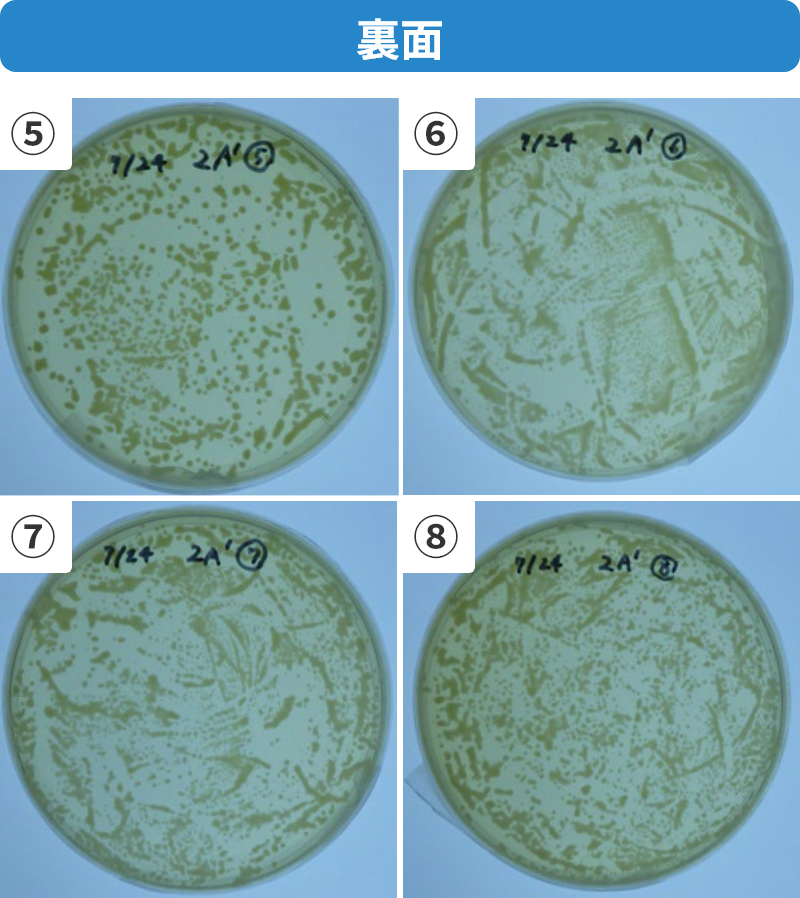
純水裏面
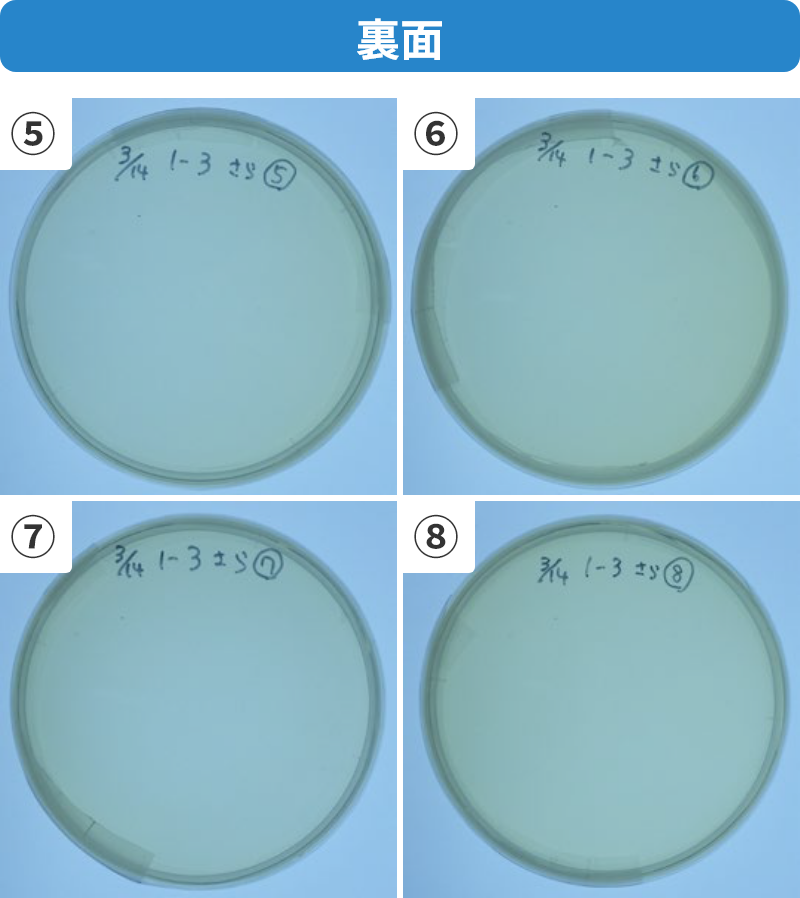
次亜塩素酸カルシウム水溶液裏面

~果菜類の採集・花卉のお手入れに~
ハサミを開閉するたびに、刃先に除菌液を自動的に噴射することで、手作業で除菌をする必要がなくなり、作業負担を大幅に削減することができます。作業中、上下どんな角度で作業しても噴射されます。
の特長
-
切るたびに自動的に刃先に除菌液が噴射されます。
-
どのような角度でハサミを使用しても除菌液が噴射されます。
-
除菌液の噴射は「ストレート」で、
霧状になって作物等に広がることはありません。
参考:噴射機能確認
トマトのかいよう病菌で、純水と次亜塩素酸カルシウムを用いてシュットくんの噴射機能についてラボ検討を行いました。
評価方法
本商品の薬液噴射機能でハサミの刃全面に除菌液が付着するか評価した。
-
ハサミを10回開閉し、刃先に十分除菌液を付着させます。
-
ハサミの刃先の裏表にトマトのかいよう病菌を付着させます。
-
ハサミを1回閉じて除菌液を1回噴射させます。
-
その後綿棒で刃先の裏表の菌体を拭き取ります。
-
それを培地で培養します。
評価方法
薬液①:純水
除菌液として純水を用いた場合は、かいよう病菌が刃先に残っていました。
薬液②:次亜塩素酸カルシウム水溶液
次亜塩素酸カルシウムを用いた場合はかいよう病菌は検出されませんでした。
刃先に除菌液がしっかりと付着していたと考えられます。
※今回の結果はラボ実験の結果です。完全な除菌を保証するものではありません。
の使用方法
-
薬液ボトルを取り外す
薬液ボトルを持ち反時計回りに回してハサミから取外す。
-
可動弁を押し下げる
付属の操作棒を薬液ボトルの開口部から挿入し可動弁を押し下げます。
-
除菌液を注入する
薬液ボトルの開口部から、除菌液をゆっくりと注入する。
-
薬液ボトルを取り付ける
薬液ボトルをハサミの給水ポンプに時計回りで止まるまでねじ込みます。
-
空気を取り除く
約15回ハサミを開閉し、薬液ボトルと送液チューブ内の空気を除いてから使用を開始してください。空気を除く際にノズルから除菌液が噴射されますのでご注意ください。使用開始前に刃先に除菌液を十分付着させてから作業開始してください。
使い方を動画でもチェック
の
保管・メンテナンス方法
-
薬液ボトルを取り外す
ハサミから薬液ボトルを外します。
-
チューブ内の除菌液を除く
ハサミを数回、空切りして送液チューブ内に残っている除菌液を除きます。
-
除菌液等を拭き取る
乾いた布で汚れや水分、除菌液等を拭き取ります。拭き取り後は錆防止のため刃物用油を刃に塗ることを推奨します。
※刃による切創に十分注意してください。 -
ボルトの緩みを確認する
ボルトの緩みを確認します。緩んでいた場合は3mmの六角レンチ(別売り)で締めてください。
-
キャップで刃をとめて保管する
保管時はハサミを閉じた状態でキャップで刃をとめて保管してください。
使い方を動画でもチェック
安全上のご注意
-
ねじ込みが不十分な場合、液漏れやボトル内に気泡が発生し、噴射装置が正しく機能しない場合があります。
-
薬液補充時や薬液ボトル装着時は、除菌液がこぼれるおそれがありますので、手袋を装着して作業してください。
-
本製品は、果菜類の摘果・採果の目的で開発されております。刃こぼれの原因となりますので、硬いものは切らないでください。
セット内容
主な仕様
| 外形寸法 | 176㎜×52.5㎜×47㎜ | |
|---|---|---|
|
||
| 重量 | 約195g | |
| 材質 | ハサミ刃 | 高硬度ステンレス鋼 |
| 薬液ボトル容量 | 15mL | |
| 液吐出量 | 約0.05mL/ショット(約250~280回/満充填) | |